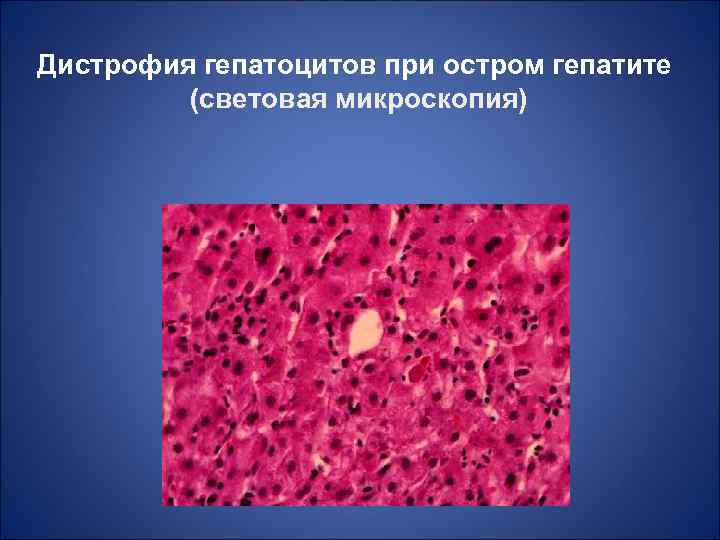
Дистрофия гепатоцитов при остром гепатите (световая микроскопия)

Вирусы гепатита.ppt
- Количество слайдов: 78

Возбудители вирусных гепатитов человека (ВГЧ) СПб. ГУ 2015

Вирусные гепатиты группа антропонозных болезней, вызываемых облигатно гепатотропными вирусами, с разнообразными механизмами заражения, характеризующихся преимущественным поражением печени с развитием общетоксического синдрома, гепатоспленомегалии, нарушениями функции печени и желтухой. Печень - рекордсмен по количеству выполняемых функций. При инфекционных гепатитах не происходит обезвреживание – токсических веществ, нарушаются пищеварение, углеводный, липидный обмены, синтез желчных кислот, многих белков плазмы крови — альбуминов, альфа- и бета-глобулинов, транспорт белков для различных гормонов и витаминов, и их синтез; депонирование витаминов и катионов железа, меди и кобальта. Иммунодефицит!!! Нарушения микробиоты!!!!

Распространенность • Согласно данным ВОЗ в настоящее время на земном шаре разными вирусами гепатита инфицировано ~ 2 млд. человек. Это, по крайней мере, в 100 раз превышает распространенность ВИЧ инфекции. • В бывшем СССР – 1 млн больных с ВГ в год, особенно Узбекистан

Историческая справка • V в. до н. э. , Гиппократ - первые упоминания о желтухе. • 1888 г – С. П. Боткин сформулировал представление об инфекционном характере катаральной желтухе. • 1962 -64 гг – Б. Блюмберг открыл “австралийский антиген” (ВГВ) • 1970 г – Д. Дейн обнаружил вирус гепатита В в сыворотке и в ткани печени. • В 1973 г. S. Feinston, A. Kaipican и R. Pursell выявили ВГА в фекалиях больного. • 1977 г – М. Ризетто открыл дельта-антиген – возбудитель гепатита D (ВГD). 1982 г. М. С. Балаян с соавт. выявил вирусоподобные частицы в фекалиях больного вирусным гепатитом Е и подтвердил самостоятельность данной нозологической формы в опыте c самозаражением. В дальнейшем были открыты вирусы гепатита С, TT, Sen, G, F.

Симптомы, характерные для вирусных гепатитов • - нарушение пигментного обмена - возрастает количество билирубина (его избыток, откладываясь в тканях даёт желтушность) • Пожелтение кожных покровов и слизистых.

Спецефические именения при ВГ • массивное повреждение • клеток печени - гепатоцитов - влечёт за собой выход в кровь содержащихся в этих клетках ферментов. • ДО появление желтухи содержание аланиламинотрансферазы (Ал. Ат) и аспартатаминотрансферазы (Ас. Ат) при остром гепатите или обострении хронического возрастает в крови в десятки раз. • В моче ещё в дожелтушном периоде • увеличивается количество уробилиногена
Дистрофия гепатоцитов при остром гепатите (световая микроскопия)

Дистрофия гепатоцитов при хроническом активном гепатите (световая микроскопия)

Жировая дистрофия гепатоцитов (световая микроскопия)

Некроз гепатоцитов (световая микроскопия)

Процесс дезорганизации клеточных мембран • распространяется на внутриклеточные органеллы, • разрушаются мембраны лизосом, • нарушается регулируемое поступление протеолитических ферментов (гидролаз, РНК-азы, ДНК-азы и др. ) в цитоплазму, что влияет на процесс непрерывного обновления клеток, • изменяются функции мембран гепатоцитов , • и вслед за этим развивается дисфункция клеток • .

Диагностика ВГ • Серологические исследования (Аг и/или АТ) • Генетические методы (ПЦР, РТ-ПЦР) • При хронических гепатитах ценным методом является цитологическое исследование материала, полученного при биопсии печени. Этот метод позволяет оценить степень и характер повреждения гепатоцитов.

Принципы классификации гепатитов • Острые и хронические (≥ 6 месяцев, В, С, D) • Инфекционные (вирусные, бактериальные, протозойные) токсические, аутоиммунные, лекарственные, криптогенные • Принципы классификации ВГ • ВГЧ с парентеральным механизмом передачи инфекции • Blood born hepatitis virus • ВГЧ с энтеральным механизмом передачи инфекции • Food born hepatitis virus • Онкогенные и «неонкогенные» • ВГВ и ВГС → 57% случаев - цирроз печени, 78% случаев - первичный рак печени.

Основные отличия ВГЧ с парентеральным и энтеральным путем передачи инфекции • Более тяжелое течение заболевания ВГЧ с парентеральным механизмом, чем с энтеральным путем передачи инфекции • Почти всегда с хронизацией процесса и угрозой летального исхода

• 1. ВГА (HАV) – сем. Picornoviridae (+1 н. РНК) • 2. ВГЕ (HЕV) – сем. Hepeviridae (ранее Caliciviridae) (+1 н. РНК)

Вирус гепатита А Hepatovirus Picornoviridae, сферические частицы диаметром 27 -30 нм, икосаэдрический тип симетрии + РНК, суперкапсид – VP 1 -VP 3 – капсид - «антиген вируса гепатита А (HAAg)» VP 4 – связан с РНК 1 серотип

Характеристика ВГА • Единственный вирус гепатита, который культивируется in vitro. Склонен персистировать в # in vitro. In vivo оказывает ЦПД, один из самый устойчивый из всех ВГ к действию физико-химических факторов (100 град. – 5 мин, чувствителен к формалину и УФ -излучению) устойчив к р. Н 3 -10. • Модель - обезьяны шимпанзе и мармозеты

Эпидемиология • ГА – антропонозная инфекция • Источник – больные в конце периода инкубации, продромальном периоде и в начальной фазе периода разгара болезни • Значительная эпидемиологическая опасность – лица со стертой клинической картиной • Механизм заражения – фекально-оральный • Пути передачи – водный, алиментарный, контактно-бытовой

ВГА вызывает инфекионный эпидемический гепатит =Болезнь Боткина • с ВГА контактируют 70 -90% населения. • 80% людей после 40 лет с АТ. • В районах с низкой санитарией инфицирование в детстве, детская инфекция –школьники начальных классов. В нашей стране 70 % гепатитов.

Эпидемиология

Патогенез ВГА • • И. П. 10 -50 дней Не размножается в энтероцитах , а сразу транспортируется через воротную вену в печень –ж. п. кишечник. Пищеварительный тракт ворота, через которые входит и выходит ВГА Проникновение в клетку – образование в результате трансляции гигантского полипротеида — нарезается при помощи клеточных протеаз --- вирусные протеазы для вычленения элементов капсида и вирусная РНК-полимераза для репликации Антитела появляются уже в инкубационный период, блокируя распространение вируса. Наиболее заразен в инкубационный период. Объем повреждений локальный некроз, с развитием клинического гепатита больной не заразен и быстро выздоравливает.

Патогенез Заражение первичная репликация вирусемия (общетоксический синдром) диссеминация вируса и накопление в печени прямое цитопатическое действие вируса повреждения гепатоцитов нарушение клеточного метаболизма гипергидратация клетки снижение биологического потенциала.

ВГА • Диагностика : обнаружение в фекалиях: микроскопия имм. фл. или эл. , серодиагностика (ИФА, РНГА) , парные сыворотки Ig. M! Исчезают через 4 месяца (Ig. G, перенесенный ранее процесс, остается на годы). • обнаружение HAAg , • ОТ-ПЦР • Лечение: вакцина (убитая) иммунитет до 10 лет для людей, выезжающих в неблагопритные регионы, Ig


Вирус гепатита Е =ВГЕ=HEV • Hepeviridae Hepevirus • РНК+ калициподобный вирус икосаэдрические тип симметрии 27 -34 нм, простой, относительно неустойчив к факторам о. с. , менее чем ВГА устойчив к термическим и химическим воздействиям

Эпидемиология • Вирусные частицы, подобные ВГЕ человека и/или антитела к нему, обнаружены у кабанов и свиней, у оленей, мелких грызунов. Выявление антител к ВГЕ у собак, кошек, коров позволяет предположить циркуляцию ВГЕ среди этих животных. Водный способ передачи в странах с тропическим и субтропическим климатом. • Механизм: Фек-ор. , только люди (чаще 15 -25 лет). Летальность 0, 4%. Смерть новорожденных 20 -25%. • В отличии от ВГА иммунитет кратковременный

• Диагностика: как при ВГА. Специфическая диагностика - серологические методы – anti. HЕV-Ig. M, в не эндемичных районах (Северо-Запад РФ) – выявление HЕVAb • Профилактитка : • Вакцины нет • М. С. Балаян (1982) выявил вирусоподобные частицы в фекалиях больного вирусным гепатитом Е и подтвердил самостоятельность данной нозологической формы в опыте самозаражением.

• • ВГВ (HBV) – сем. Hepadnaviridae (2 н. ДНК) ВГС (HCV) - сем. Flaviviridae (+1 н. РНК) ВГD (HDV) - сателлит ВГВ, но РНК содержащий ВГG (HGV) - +1 н. РНК, похож на Flaviviridae, еще не определено до конца его таксономическое положение, близок к ВГС, но не дает хронизации.

Вирус гепатита В • • Hepadnaviridae обнаружены Дейном 1970 г. = частицы Дейна Двунитевая с однонитевым участком (15 -60% цепи) Вирусзакодированные белки: пртеинкиназа и ДНК-полимераза • ВГВ – один из мельчайших оболочечных вирусов человека. Имеет сферическую форму, Ø 42 -45 нм. В электронном микроскопе отчетлива видна сердцевина, белковый нуклеокапсид, снаружи окруженный суперкапсидом, который в основе своей представляет липопротеин – новую мембрану пронизанную гликопротеинами.

Распространенность HBV в мире HBs. Ag (+), %% Тайвань 10. 0 -13. 8 Вьетнам 5. 7 -10. 0 Китай 5. 3 -12. 0 Африка 5. 0 -19. 0 Филиппины 5. 0 -16. 0 Таиланд 4. 6 -8. 0 Япония 4. 4 -13. 0 Индонезия 4. 0 Южная Корея 2. 6 -5. 1 Высокая (≥ 8%) Индия 2. 4 -4. 7 Средняя (от 2% до 8%) Россия 1. 4 -8. 0 США 0. 2 -0. 5 Распространенность HBs. Ag Низкая (< 2%) Mast EE, et al. MMWR Recomm Rep. 2006; 55: 1 -33. Custer B, et al. J Clin Gastroenterol. 2004; 38(10 suppl): S 158 -S 168.

HBV-инфекция - важнейшая причина заболеваемости и смертности в мире • • > 2 миллиардов инфицированы[1] 4 млн случаев острой HBV-инфекции в год[1] 1 млн смертей ежегодно[1] 350 -400 млн «хронических носителей» [1] – 25% из них умирают из-за ХВГВ, циротической стадии ХВГВ, ГЦК[1] – Около 75% «хронических носителей» являются жителями Азии[2] • НВV-инфекция является вторым наиболее серьезным канцерогеном в мире (после табака)[3] 1. WHO. Hepatitis B. 2002. 2. Maynard JE, et al. In: Viral Hepatitis and Liver Disease. New York: Alan R. Liss, Inc. 1988. 3. CDC. Epidemiology & prevention of vaccine-preventable diseases. The Pink Book. 8 th ed.

Эпидемиология • Источник инфекции – больные манифестными и бессимптомными формами острого и хронического ГВ. Удалось идентифицировать подобные вирусы у различных животных: североамериканских сурков, земляных белок, пекинских уток и других птиц. • Механизм заражения – парентеральный крово-контактный (гемоконтактный) • Пути передачи – естественные (вертикальный/перинатальный, половой, горизонтальный) и искусственные (при нарушении целостности кожи и слизистых) • НВV-инфекция в 100 раз более контагиозная инфекция по сравнению с ВИЧ-инфекцией (CDC. MMWR. 2001; 50: RR-11. )

Пути передачи ВГВ у заболевших острой формой Половой 51, 5% Парентеральное введение наркотиков 30, 1% Неустановленный 10, 1% Контактно-бытовой 4, 9% Заражение в ЛПУ 3, 3% Вертикальный 0, 1%

Потенциальные источники распространения HBV - инфекции 1. Доноры и реципиенты крови, тканей. 2. Наркоманы с внутривенным введением наркотиков. 3. Медицинские работники (хирурги, стоматологи, лабораторные службы). 4. Больные и персонал отделений гемодиализа, реанимации, болезней крови, онкологических и туберкулезных диспансеров. 5. Больные с хроническими заболеваниями печени неясной этиологии.

Потенциальные источники (продолжение) 6. Гомосексуалисты. 7. Лица, ведущие неупорядоченную половую жизнь при незащищенном сексе (промискуитет). 8. Дети рожденные от инфицированных матерей. 9. Больные и персонал учреждений для умственно отсталых. 10. ВИЧ – инфицированные. 11. Лица из гиперэндемических очагов, беженцы.

Схемы строения ВГВ

Элекронограмма Вируса гепатита В

Геном ВГВ -Кольцевая молекула 2 Н ДНК 2 неравноценные цепи «+» цепь ДНК на 1/3 короче «-» цепи ДНК • 4 перекрывающиеся рамки считывания, кодирующие ДНК-полимеразу и 3 основных типа белка нуклеопротеина: • 1. вирусный Pol- комплекс • 2. поверхностный гликопротеин – белок суперкапсида, который является поверхностным АГ HBSAg (s от surface – поверхность) • 3. белок сердцевины (нуклеокапсида) - HBСAg (с от соre – сердцевина) – сердцевинный АГ. • 4. белок активирующий экспрессию всех генов вируса – белок Х – HBХAg (х от неизвестный – долго не знали его функции). •

Вирусный Pol- комплекс полифункциональный фермент • 1. обратная транскриптаза • 2. ДНК-полимераза • 3. РНК-аза • является продуктом гена Р

HBSAg Содержит протективные В-эпитопы (воспринимаемые В-лимфоцитами) Выделяют 4 основных субтипа: adw, adr, ayw, ayr Все субтипы АГ оболочки: (a, y, d, w, r) содержат одинаковую «антигенную детерминанту" - "a" антиген важен для создания вакцин имеет некоторые различия в последовательности аминокислот

1 -й вирусный белок HBSAg - гликопротеин Состоит из нескольких суперкапсидных полипептидов секретируется в кровь Агрегаты: сферы - 22 нм, филаменты – 200 -500 нм Продукт гена S, а также пре. S 1 и пре. S 2 обеспечивает взаимодействие с рецепторами на гепатоцитах (зоны полимеризованного альбумина)

2 -й вирусный белок HBСAg не секретируется в кровь • Главный белок нуклеокапсида • Продукт гена С и фрагмент пре. С • Еще один белок из HBСAg - HBе. Ag • HBе. Ag - продукт гена С 1 - входит в мембрану и секретируется в кровь, его обнаружение отражает репликативную активность ВГВ

3 -й вирусный белок HBХAg секретируется в кровь • Продукт гена Х • Входит в состав сердцевины • Трансактиватор вирусных и клеточных генов, способствует развитию патологических процессов в печени • Регулятор инсерционного мутагенеза • Участвует в злокачественном перерождении инфицированных гепатоцитов и образовании гепатомы

Устойчивость ВГВ к хим. и физ. воздействиям Устойчив к низким и высоким То Многим ф/х факторам В комн. условиях устойчив – 3 мес. В холодильнике – 6 мес. Кипячение – 30 мин. Противостоит действию многих дезинфектантов. 1 -2% хлорамин – гибель 2 час. 1, 5% формалин- 7 сут.

Жизненный цикл вируса гепатита В и механизм действия ингибиторов обратной транскриптазы

Репликация ВГВ с подключением обратной транскрипции • Достраивание дефектной +ДНК-цепи при попадании ВГВ в цитоплазму • Перенос полной 2 Н ДНК в ядро • Синтез полной копии РНК (прегенома) на +ДНК нити и коротких копий РНК клеточной РНК-полимеразой • Обратная транскрипция с РНК на ДНК вирусной обратной транскриптазой после попадания прегеномной РНК в цитоплазму и включения ее в нуклеокапсид • Разрушение РНК-прегенома РНК-азой вируса • Построение на -ДНК новой дефектной +ДНК вирусной ДНК-азой

Особенности репликации ВГВ • Необходимость перманентного достраивания +ДНК цепи • обратная транскрипция с РНК на ДНК: повышает вероятность ошибок синтеза приводит к образованию квази-видов Может усиливать собственную репликацию и ВИЧ-1 типа!!!!!

Патогенез Инкубационный период: 6 недель - 6 мес. Отсутствие цитопатического воздействия вируса на гепатоциты Повреждающее действие ВГВ иммуноопосредованно: В основе изменений печени - цитолиз гепатоцитов: аутоиммунный процесс Электролитный дисбаланс Дезорганизация мембран Дисфункция клеток

Цитолиз гепатоцитов • Нарушение метаболических процессов в печени связано с: • активацией прооксидантных и угнетением антиоксидантных систем клетки • накоплением свободных радикалов • усилением перекисного окисления липидов • разрушением мембран • перераспределением веществ по градиенту концентрации→электролитный дисбаланс

Электролитный дисбаланс Набухание гепатоцитов Изменение р. Н внутри клеток Разобщение процессов окислительного фосфорилирования Уменьшение выработки энергии Нарушение синтеза белков и утилизации глюкозы В итоге снижение детоксицирующей функции печени


Критерии оценки фазы заболевания HBs. Ag Анти. HBs Анти. HBc HBe. Ag анти-НВе + - Ig. M + - Высокоинфекционный острый гепатит В + - Ig. G + - Высокоинфекционный хронический гепатит В + Затухающий или хронический гепатит В с низкой инфекционностью **** + + Ig. G - Заключение (диагноз) + +/- +/- Инфекция двумя различными подтипами HBV или текущая сероконверсия. Встречается редко. - - Ig. M +/- Острый гепатит или анти-HBc "окно". - - Ig. G - +/- Застарелый гепатит В или носительство HBs. Ag с низкой репликацией. - + Ig. G - +/- Затухающий острый гепатит В - + - - - Лечёный гепатит В. Реакция на введение вакцины против гепатита В. Ошибочный анализ.


Диагностика • Раннее подтверждение – обнаружение в крови HBs. Ag, HBe. Ag, anti-HBc Ig. M, HBV DNA • Благоприятному циклическому течению соответствует исчезновение HBe. Ag и HBs. Ag с появлением anti-HBe и anti-HBs. Анти-HBs сохраняется пожизненно, являясь индикатором резистентности к HBV. Их определение обязательная процедура при вакцинации против ГВ.

Лечение HBV 1. Синтетические нуклеозиды (ламивудин, энтекавир, телбивудин, адефовир, тенофовир, эмтрицитабин) 2. Иммунотерапия : интерферон гамма и альфа, интерлейкины 1, 2, 12, тимозин, глютоксим, гранулоцитарно-макрофагальный колониестимулирующий фактор. • иммунодепрессанты+ • Специфический иммуноглобулин • Профилактика: Специфический иммуноглобулин, вакцина, содержит поверхностный антиген

Вакцины против HBV • 1. Рекомбинантная дрожжевая «Комбиотех» • 2. Бубо-М (от дифтерии, столбняка, гепатита В) Россия • 3. Бубо-Кок (от дифтерии, коклюша, столбняка, гепатита В) Россия • 4. Энджерикс (Российско-Бельгийская) • H-B-VAX=II (США) • 5. Эувакс (Южная Корея) • 6. Шанвак В (Индия)

Вакцинация против ВГВ: Уменьшение числа случаев и смертности от ГЦК среди детей 6 -14 лет* 0. 8 0. 6 0. 4 0. 8 0. 70 0. 57 0. 36 Смертность 1 на 100, 000 детей (6 -14 лет) на 100, 000 детей 1 Заболеваемость/Incidence 0. 80 0. 58 0. 6 0. 4 0. 2 0 0 0. 34 1981 -86 1986 -90 1990 -94 1981 -86 *Национальная программа вакцинации в Тайване начата в июле 1984. Chang MH, et al. N Engl J Med. 1997; 336: 1855 -1859. 1986 -90 1990 -94

Вирус гепатита D • - РНК – ковалентно-замкнутая молекула, самый маленький геном из всех вирусов животных, дефектный вирус саттелит. Поверхностную оболочку формирует HBs –Ag ВГВ • Термоустойчив, выживает при УФоблучении. • В отличии от вироидов на основе м. РНК (копии РНК ВГD) , синтезируется дельта антиген. Прямое цитотоксическое действие. Иммунитет нестойкий.

Вирус гепатита С содержит однонитевую +РНК и относится к семейству флавивирусов. Однонитевая РНК вируса содержит около 10. 000 нуклеотидов. 3 структурных белка: 1. структурный белок нуклеокапсида (белок C) 2. мембранный (белок М) 3. поверхностный (белок E). Белки обладают сходными антигенными свойствами, поэтому их общим маркером являются иммуноглобулины анти-HCV-core-Ig. Выделены также 5 неструктурных (NS) белков, принимающие участие в репликации вируса.

Вирус гепатита С Диаметр 50 нм, одетые Рецепторы – E 1, E 2 • 1 Н РНК содержит около 10000 нуклеотидов • 3 структурных белка: 1. структурный белок нуклеокапсида (белок C) 2. мембранный (белок М) 3. поверхностный (белок E) Белки обладают сходными антигенными свойствами, поэтому их общим маркером являются иммуноглобулины анти-HCV-core-Ig Выделены также 5 неструктурных (NS) белков, принимающих участие в репликации вируса

HCV генотипы и субтипы 2 5 1 4 3 6 (P. Simmonds, Philos Trans R Soc Lond B Biol Sci 2001; 356: 1013 -26)

Особенности репродукции ВГС


Географическое распределение HCV генотипов 1 a, 1 b 2 a, 2 b, 2 c, 3 a 1 a, 1 b 2 a, 2 b, 3 a 2 a 4 4 1 b, 3 a 1 b 1 b, 6 3 b 1 a, 1 b, 2 b, 3 a 5 a 1 b, 3 a Fang et al Clin Liver Dis 1997

Распределение генотипов HCV 1 a 50. 0% 1 a/2 1. 5% 4 c/4 d 1. 5% 4 a 1. 5% 2 a/2 c 1. 5% 2 b 3. 0% 1 b 22. 7% 1 a/1 b 7. 6% 3 a 9. 1% Sherman et al. CID 2002.

Патогенез ВГС • Длительный инкубационный период – 50 сут. • При попадании в кровь вызывает виремию • Передача через кровь и • другие биологические жидкости • Вызывает хроническую инфекцию, ведущую к циррозу или к саркоме САРК ОМА

Хроническая HCV инфекция • Поражено около 300 млн человек во всём мире. • Самая частая причина хронических заболеваний печени. • Резко увеличивает риск развития печёночной недостаточности и первичного рака печени. • Самая частая причина для пересадки печени в США. • «ВГС - Убийца с мягкими лапками»

HCV маркеры • HCV генотип: – важная характеристика тяжести HCV инфекции • HCV РНК: – маркер HCV репликации • общий HCV core Ag: – суррогатный маркер HCV репликации • Anti-HCV AB: – маркер бывшей или существующей инфекции

Вирус гепатита С Иммуно-флюоресцентный метод

Вирус гепатита G • Выделен в 1995 г Hepacivirus Flaviviridae похож на С вирус, в геноме структурные Е 1 и Е 2 и неструктурные участки генома , но нет вариабильного участка. Наличие серцевинного белка (core) • GB вирус типа С (по инициалам больного) • РНК белок Е-2 иммуногенен. • Эпидемиология: • Механизм: парентеальный , • Интерес к этому вирусу связан с близостью свойств ВГG и ВГС. Это открывает возможность использования вируса гепатита G и вызванной им экспериментальной инфекции в качестве модели изучения гепатита С. В отличие от гепатита С гепатит G можно моделировать на нечеловекообразных обезьянах, что значительно удешевляет проведение таких исследований, прежде всего востребованных при разработке вакцины против гепатита С.

• . Установлено, что ко-инфекция GBV-C у ВИЧ- инфицированных людей приводит к снижению смертности и улучшению клинических показателей инфекции. Кроме того, достоверно повышалась эффективность высокоактивной антиретровирусной терапии. Позитивное действие GBV-C/ВГG объясняют тем, что оболочечные белки этого вируса связывают молекулы CD 81+. На Т-клетках и вызывают дозозависимую секрецию RANTES (естественного лиганда CCR 5), который, в свою очередь, вызывает погружение CCR 5 вглубь клетки-мишени, блокируя проникновение ВИЧ.

ТТ вирусы гепатита (ТТV) -, «Torque teno virusis» , или вирусы «тонкого ожерелья» ТТV — представляет собой частицу размером 30 -50 нм. Геном вируса представлен ДНК, имеющей кольцевую структуру протяженностью около 3800 нуклеотидов. Вирус ТТ можно назвать первым членом нового семейства вирусов, которое могло быть обозначено Circinoviridae (от латинского «circinatio» — «описывающий круг» ), род Anellovirus. Сравнение штаммов ТТ вируса позволило выявить более 20 генотипов вируса. Кроме того, были дополнительно идентифицированы агенты, близкие к этому вирусу и имеющие общую систему организации генома. Выявлены изоляты вируса, обозначенные YONBAN и SANBAN, отличающиеся по последовательностям ДНК от «прототипных» штаммов ТТV более, чем на 50%. Значительно большие различия зарегистрированы в изоляте вируса, обозначенном — «малый TT вирус» . Поиск вариантов ТТV позволил обнаружить несколько новых вирусов: TCHN-A, -B и TUS 01, L 02, KAV. По структуре генома и свойствам эти вирусы близки к «прототипным» штаммам вируса ТТ. Сегодня не понятен биологический смысл столь широкого разнообразия вирусов ТТ. Определение частоты выявления ДНК ТТV продемонстрировало повсеместное распространение этого

SEN вирус (SENV) «Первая информация об этом вирусе неожиданно появилась не в научном издании, а в газете «Нью-Йорк Таймс» (20 июля 1999 г. ). Даниил Пери, сотрудник итальянской фирмы «Dia. Sorin» сообщил о своих исследованиях, в результате которых был идентифицирован ранее неизвестный вирус. В сыворотке крови больного СПИД во время подъема активности сывороточных трансаминаз при помощи одного из вариантов ПЦР обнаружены последовательности ДНК, которые ранее у него не выявляли. Отсутствие в крови маркеров известных вирусов, способных вызвать гепатит, позволило расценить подъем активности ферментов как случай гепатита «ни А, ни G» и предположить, что выявленный агент представляет собой до сих пор неизвестный вирус, ответственный за развитие гепатита «ни А, ни G» . По сложившейся традиции по инициалам первого больного, у которого был идентифицирован этот агент, вирусу присвоено обозначение SEN. Молекулярно-вирусологические исследования SENV установили, что это небольшой безоболочечный вирус, содержащий одноцепочечную кольцевую ДНК (приблизительно 3800 нуклеотидов). По физикохимическим и структурным характеристикам этот вирус близок к ТТV и может быть классифицирован как член семейства Сircoviridae. Исследования изолятов SEN вируса продемонстрировали существование как минимум восьми генотипов: A, B, C, D, E, F, G и Н. Несмотря на накопление информации о SEN вирусе и широте его распространения, главный вопрос о его этиологической роли в возникновении гепатита остается открытым. Повышенная частота выявления ДНК SENV среди больных острым гепатитом “ни А, ни G” может косвенно свидетельствовать о роли этого вируса в развитии гепатита» . .

NF вирус гепатита «Сообщение об обнаружении нового вируса, вызывающего гепатит, обозначенного «NF вирус» , появилось в апреле 2006 года после обнаружения ДНК -фрагментов ранее неизвестного вирусного агента у больных гепатитом «ни А, ни Е» . Частота обнаружения у этих пациентов ДНК NF вируса составила 24, 6%, в то время как у «здоровых» доноров крови – всего 2, 8%. Исследование сывороток крови больных гепатитами С и В на наличие этого маркера вируса установило более частую регистрацию ДНК NF вируса у больных гепатитом С (24, 0% и 13, 6% соответственно). NF вирус содержит одноцепочечную, переплетенную, вирусную ДНК. Предполагают, что размер частиц этого вируса менее 0, 2 мм, так как он проходит через фильтр с порами этой величины. При ультрацентрифугировании в градиенте плотности Cs. Cl обнаружено два пика концентраций ДНК NF вируса. Эти результаты позволили предположить наличие двух форм вируса, содержащих нуклеокапсид с и без наружной оболочки. Сравнение последовательностей фрагментов ДНК NF вируса с известными к сегодняшнему дню ДНК-содержащими вирусами позволяет предположить, что вновь идентифицированный вирус близок к Рarvo- или Circo-вирусам. Дальнейшие исследования должны установить, не является ли NF вирус первым представителем нового вирусного семейства» .

Вирусы гепатита Вирус Тип нуклеиновой кислоты Размер вириона HAV HBV HCV HDV HEV + 1 н РНК -РНК +РНК 35 -40 нм 27 -34 нм 2 н ДНК +РНК 25 нм 42 нм 60 нм Суперкапсид - + + -+ чужой - Хронизация Нет Да Да Да Нет Наличие вакцины Да Да Нет Эффективна HBV вакцина Нет

Общие признаки острого вирусного гепатита Вирус HAV HBV HCV HDV HEV Инкубационный 2 -6 период недель 8 -24 недели 6 -12 недель Варьирует: коинфекци я против суперинфекции 2 -6 недель Наиболее Антиинформатив-ный HAV метод (Ig. M) диагностики Анти. HBc (Ig. M) HCV РНК* Анти-HDV (Ig. M) Анти-HEV (Ig. M)

Характеристика «новых» вирусов вызывающих гепатит и претендующие на эту роль Вирус GBV-C/HGV TTV SENV HFV Нуклеиновая кислота Одноцепочечная РНК Одноцепочечная ДНК Одноцепочечная кольцевая Одноцепочечная ДНК Семейство Flaviviridae Circoviridae Не классифицирован Род Anellovirus Размер частицы 50 нм 30 -50 нм ? ? Генотипы 6 Более 20 8 ? Хозяин Человек, обезьяны, коровы Человек Основные антигены (белки) Ag HGV Три белка ? ? Нет Нет Основное место репликации Лимфоциты, селезенка Гепатоцит, ? Устойчивость Средняя Нет данных Передача вируса Парентеральная Острый и хронический гепатит? Острый и хронический гепатит Интеграция нуклеиновой кислоты Гепатит? Фиброз Заболевание Острый и хронический гепатит легких? Апластическая анемия? Поражение желчных путей Носительство Есть (свыше 90%) Есть Наличие вакцины Нет Нет

СПАСИБО ЗА ВНИМАНИЕ!!! «Сегодня этиологическая расшифровка случаев вирусного гепатита не позволяет в 100% определить их взаимосвязь с конкретным вирусом. Существование ещё необнаруженных «новых» вирусов гепатита стимулирует дальнейший научный поиск, который может привести к неожиданным результатам» . http: //www. hv-info. ru
Вирусы гепатита.ppt